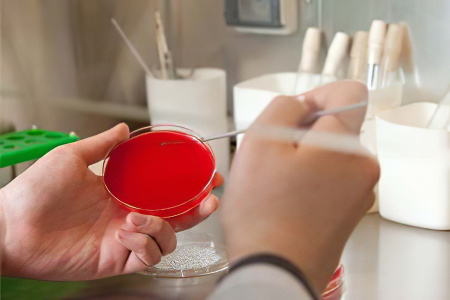
Методы диагностики туберкулеза

Презентация на тему Презентация на тему Что такое туберкулез и как с ним бороться, предмет презентации: Медицина. Этот материал содержит 10 слайдов. Красочные слайды и илюстрации помогут Вам заинтересовать свою аудиторию. Для просмотра воспользуйтесь проигрывателем, если материал оказался полезным для Вас - поделитесь им с друзьями с помощью социальных кнопок и добавьте наш сайт презентаций ThePresentation.ru в закладки!

Что такое туберкулез и как с ним бороться
Выполнил Костшевский А.А.
Учащийся группы ТО-25

Болезнь развивается после инфицирования организма человека туберкулезной бактерией Mycobacterium или палочкой Коха. Данный микроорганизм устойчив к влиянию внешней среды, высокотемпературному воздействию, долго сохраняет жизнеспособность при пониженных температурах.

Как развивается туберкулез
Туберкулез – инфекционное заболевание бактериальной этиологии. Болезнь имеет не только медицинский, но и социальный аспект: наиболее чувствительны к возбудителю туберкулеза люди с низким уровнем иммунитета, несбалансированным рационом питания, проживающие в условиях несоблюдения санитарно-гигиенических норм, плохих социально-бытовых условий. На развитие болезни влияет уровень качества жизни человека. Однако группу риска при туберкулезе составляют все слои населения, вне зависимости от возрастной и половой принадлежности.

Современная профилактика туберкулеза позволяет людям контролировать эту болезнь. На сегодняшний день применяется введение обязательной вакцинации, а также в наличии имеется ряд эффективных химических препаратов профилактики туберкулеза, что в совокупности помогает людям избежать заражения или как минимум ослабить недуг.

Так как на сегодня от осложнений более 15 тысяч людей умирают, крайне важно соблюдать все рекомендации врача относительно профилактики туберкулеза как детям, так и взрослым. Лечить такое заболевание очень долго, полное выздоровление может занять более 1 года. Поэтому лучше и проще соблюдать меры предосторожности, чем после стараться всеми силами избавиться от недуга.

Основной путь инфицирования – попадание палочки Коха воздушно-капельным путем в органы дыхания. Реже регистрируются бытовой (контактный) и трансплацентарный способы передачи инфекции. Бактерия проникает в тело через дыхательные пути, далее мигрирует в слизистую бронхов, альвеолы и с током крови разносится по организму. Для человеческого тела палочка Коха – чужеродный микроорганизм. В норме при ее появлении и размножении в организме иммунные клетки атакуют возбудителя заболевания, не допуская стадии активного размножения. Развитие болезни вероятно в двух случаях: если иммунная система подавлена, есть нарушения выработки антител, состояния иммунодефицитов, защитные силы организма ослаблены иными заболеваниями, недостаточно

Палочка Коха не считается высококонтагиозным инфекционным агентом, хотя носитель инфекции с открытой формой заболевания распространяет бактерии в окружающую среду, вероятность заболеть после контакта с возбудителем и его проникновения в организм у здорового человека крайне невысока. Туберкулёзник (туберкулезный больной) в большинстве случаев не нуждается в стационарном лечении в неактивной форме болезни и не ограничен в передвижениях, социальной активности. При постоянном бытовом контакте, в семьях, где есть больной туберкулезом человек, рекомендуется уделять внимание не только его здоровью, но и подержанию гигиены, мерам по усилению иммунитета остальных членов семьи и регулярным проверкам реакции организма на пробу Манту для выявления возможного заражения на самых ранних стадиях.

Как можно заразиться туберкулезом?
Через воздух - (аэрогенный, воздушно-капельный путь) или предметы обихода при пользовании общей с больным туберкулезом легких посудой, туалетными принадлежностями и т.д., реже через пищу (алиментарный путь).
При употреблении молочных продуктов от больного туберкулезом крупнорогатого скота.
Внутриутробное заражение плода (крайне редко) при туберкулезе у беременных.
Около 50% впервые выявленных больных выделяют возбудителя туберкулеза в окружающую среду при разговоре, кашле, чихании. Аэрозоль с мельчайшими частицами мокроты в течение длительного времени может находиться в воздухе и являться источником заражения детей и взрослых. Если больной человек не лечится, он может за год инфицировать 10 – 15 человек.

Развитие туберкулеза: признаки и симптомы различных стадий заболевания.
Как правило, нарастание проявлений туберкулеза происходит постепенно. Достаточно длительный период возбудитель не проявляет себя в организме, распространяясь и размножаясь большей частью в тканях легких. В начале туберкулеза симптомы отсутствуют. Выделяют первичную стадию, на которой преимущественно происходит размножение патогенных организмов, не сопровождающуюся клиническими проявлениями. После первичной наступает латентная, или скрытая стадия заболевания, на которой может наблюдаться следующая симптоматика:
общее ухудшение самочувствия;
усталость, упадок сил, раздражительность;
немотивированная потеря массы тела;
избыточная потливость в ночное время.
Кашель, повышенная температура тела не характерны для первых стадий заболевания, эти симптомы отмечаются на этапе обширных поражений тканей легких. При стертой картине первых стадий развития болезни диагностика возможна только методами туберкулиновых проб (Диаскин-тест, реакция на пробу Манту и т. п.) или при анализе крови на ПЦР. Следующая стадия характеризуется латентным этапом, «закрытой» формой туберкулеза, при которой не происходит выделения возбудителя в окружающую среду и, при его умеренном размножении и сопротивлении организма, выраженного вреда для здоровья не наблюдается. Латентная форма опасна возможностью перехода в стадию активной болезни, не только опасной для окружающих, но и крайне негативно влияющей на организм. Активная стадия переходит во вторичную, патогенный микроорганизм достигает этапа массового размножения и распространяется по другим органам тела. Возникают тяжелые поражения и заболевания, приводящие к летальному исходу.

Основные симптомы и признаки
Длительный кашель (более трех недель) или покашливание с выделением мокроты, возможно с кровью.
Боли в грудной клетке.
Потеря аппетита, снижение массы тела.
Усиленное потоотделение (особенно в ночное время).
Общее недомогание и слабость.
Периодическое небольшое повышение температуры тела (37,2° – 37,4°С).
Покраснение и припухлость кожи размером более 5 мм у детей и подростков при проведении пробы Манту свидетельствуют о моменте заражения, но еще не о самой болезни; в этом случае требуется углубленное обследование ребенка.

Туберкулез – одна из старейших напастей, известных человечеству. На Руси её называли «сухотной болезнью», а позднее – «чахоткой». В Древней Греции недуг прославился под именем phtisis, что означает «истощение». От этого слова и происходит современное название медицинской отрасли, изучающей проблему туберкулеза – фтизиатрии. А доктор, специализирующийся на лечении туберкулезных больных, известен всем, как фтизиатр.
Несмотря на выдающиеся успехи современной науки в области разработки диагностических средств, предупреждения эпидемий и лечения сложных инфекций победить туберкулез до сих пор не удалось. Наоборот, проблема заболеваемости этим недугом становится все острее в некоторых государствах мира. Распространение туберкулеза прямо связано с процессами глобализации и миграции, за которыми медицина развивающихся стран просто не успевает.
Россия находится на 22-ом месте в мире по уровню заболеваемости и смертности от туберкулеза, и это очень печальная цифра. Хотя за последние десять лет Минздраву удалось добиться внушительных результатов в борьбе с распространением болезни, об успехе говорить ещё рано. А чтобы обезопасить себя и своих близких, лучше вооружиться актуальной и достоверной информацией. Из этой статьи вы узнаете абсолютно все о туберкулезе: что это такое, чем вызывается, как передается, какими методами диагностируется и лечится.
Термин «туберкулез» происходит от латинского слова tuberculum («бугорок»), потому что на него похожи очаги воспаления – туберкулезные гранулемы. Вызывают это заболевание микобактерии вида Mycobacterium tuberculosis complex, то есть непосредственно mycobacteria tuberculosis (МБТ) и её ближайшие родственники. Самый главный очаг поражения – дыхательные пути (бронхи легкие), но иногда микобактерии вызывают воспаление в лимфатической, нервной и мочеполовой системе, опорно-двигательном аппарате, на коже, или даже поражают весь организм целиком (милиарная форма).
Непобедимость туберкулеза объясняется несколькими причинами:
Возбудитель болезни часто не проявляет себя годами, и даже когда воспалительный процесс начинается, человек не спешит на приём к врачу. Ранние симптомы туберкулеза легко спутать с обычной простудой или переутомлением. В итоге время оказывается упущенным, и больному приходится проходить длительное, сложное лечение;
Туберкулезные микобактерии чрезвычайно устойчивы к агрессивному влиянию внешней среды, очень долго сохраняются в жизнеспособном состоянии и заражают все новых и новых людей в таких местах, где их никто не ожидает встретить, и где от них невозможно избавиться никакими санитарно-гигиеническими методами;
Возбудитель туберкулеза быстро мутирует, приобретая устойчивость к антибиотикам. Причем, мутация может происходить уже в организме больного человека по ходу течения болезни. Это сильно осложняет и продлевает лечение, а при отсутствии успеха может стоить человеку жизни. Например, лишь за 2008 год по данным ВОЗ в мире туберкулезом заболели 9 млн человек, и треть из них погибли.
Современным археологам не раз приходилось извлекать из древних захоронений человеческие останки с признаками туберкулезного поражения костей, причем, некоторые скелеты принадлежат людям, жившим на Земле за 3000 лет до нашей эры. Поэтому можно с уверенностью утверждать, что туберкулез – ровесник человечества и его неизменный печальный спутник.
Хотя контагиозная природа этого заболевания была доказана лишь в конце девятнадцатого столетия, люди очень давно догадались, что туберкулез заразен. Например, вавилонские «Законы Хаммурапи» позволяли мужу в одностороннем порядке расторгнуть брак с женой, если у нее есть признаки туберкулеза. А древнеиндийские «Законы Ману» и вовсе запрещали мужчинам жениться на таких женщинах. Правитель Венеции издал закон, предписывающий горожанам докладывать обо всех туберкулезных больных «куда следует».
Первые научные описания туберкулеза принадлежат перу Гиппократа. Хотя знаменитый греческий целитель и отличался глубоким умом и невероятной наблюдательностью, насчет туберкулеза он ошибся. Гиппократ подметил, что этим недугом обычно страдают члены одной семьи, и сделал ложный вывод о наследственной природе туберкулеза.
Еще один известный врачеватель, Авиценна, живший позднее, указывал в своих записях на прямую связь между туберкулезом и плевритом, а также на тот факт, что возникновению недуга способствует неблагоприятная среда и низкий социальный статус: туберкулезом болеют бедные люди, которые плохо питаются, живут в грязи и занимаются каторжным трудом. Авиценна был уверен, что болезнь заразна, но не знал, как от нее излечить.
В древнерусских летописях имеются упоминания о туберкулезе лимфатической системы. Этим заболеванием страдал киевский князь Святослав Ярославич в 1076 году. Лечение в те времена было хирургическим: очаги воспаления вырезали, а места затем прижигали. Конечно, эта методика не помогла лекарям исцелить князя.

Характер эпидемии болезнь приобрела в XVII – XVIII веке, когда началось активное строительство городов, развитие промышленности, торговли и транспорта. Люди путешествовали, отправлялись на заработки, и попутно разносили смертоносную бактерию. В середине семнадцатого века на одном только Британском полуострове примерно 20% смертей приходилось на туберкулез. Ситуация в остальной Старой Европе была не лучше.
Тогда же начались первые медицинские исследования, направленные на установление природы туберкулеза и поиск методов лечения. Доктор Франциск Сильвий, живший в XVII веке, впервые обнаружил туберкулезные гранулемы при вскрытии умершего от чахотки больного, но ошибочно принял их за увеличенные лимфоузлы. Однако потом М. Бейлли (1761-1821) доискался до истины и понял, что бугорки – это форма проявления болезни и основа дальнейшего распространения воспаления.
Последователь доктора Бейлли, французский ученый Рене Лаэннек (1781-1826), впервые ввел термин «туберкулез», а также описал несколько типов этого заболевания. Он также предложил использовать аускультацию легких, что послужило прорывом в диагностике. Русский врач Г.И. Сокольский (1807-1886) был знаком с трудами Лаэннека и опирался на них в своей научной работе. Итогом стала книга «Учение о грудных болезнях», увидевшая свет в 1838 году. В ней Сокольский впервые описывает кавернозную, инфильтративную и диссеминированную формы туберкулеза, правда, под другими терминами.
Большой вклад в разгадку природы туберкулеза внес французский судовой врач Жан-Антуан Вильмен. В 1865 году во время плавания он обнаружил, что один из матросов болен туберкулезом, и стал свидетелем того, как те же симптомы постепенно возникали у других членов экипажа. Чтобы подтвердить догадку о заразности болезни, доктор собрал инфицированную мокроту и пропитал ею подстилку, на которой жили морские свинки. Животные заразились туберкулезом и погибли.
Немецкий патологоанатом Юлиус Конгейм в 1879 году подтвердил гипотезу Вильмена с помощью ещё одного опыта на животных: он внедрял фрагменты инфицированного туберкулезом человеческого легкого в глазную камеру кроликов, после чего наблюдал там развитие туберкулезных гранулем.
Однако лишь в 1882 году стало доподлинно известно, как именно смертельная болезнь распространяется и поражает миллионы людей. Немецкий врач Роберт Кох посвятил 17 лет жизни изучению этого вопроса, и, наконец, смог обнаружить и рассмотреть опасную микобактерию под микроскопом, после того, как окрасил инфицированный образец метиленовым синим и везувином. Затем доктор сумел выделить чистую бактериальную культуру и заразить ею подопытных животных. В честь первооткрывателя туберкулезная микобактерия получила название «палочка Коха». А раствор с бактериальной культурой, названный «туберкулином», используется в диагностических целях до сих пор.
Более чем в 90% случаев туберкулез локализуется с легких, но существуют также костные, мочеполовые, кожные, мозговые, кишечные, милиарные разновидности заболевания, поэтому принято выделять две формы туберкулеза:
Исходя из того, заболел ли человек впервые, или болезнь после ремиссии вновь перешла в активную стадию, выделяют два типа туберкулеза:
Это острая форма заболевания, которая возникает сразу же после попадания в кровь возбудителя. Первичным туберкулезом часто болеют дети до пятилетнего возраста, поскольку их не до конца сформировавшаяся иммунная система не может справиться с атакой туберкулезных микобактерий. Хотя болезнь протекает тяжело и имеет ярко выраженную симптоматику, для окружающих на данном этапе больные не заразны.
В легких образуется первичный очаг поражения – небольшая гранулема. Дальше события могут развиваться либо по благоприятному, либо по печальному сценарию. В первом случае туберкулезная гранулема самостоятельно заживает. Иногда человек даже не осознает всей серьезности проблемы, списывая свое недомогание на усталость и простуду. Потом во время рентгенологического обследования у него в легких обнаружат «сюрприз» - зарубцевавшуюся гранулему.
Во втором случае гранулема увеличивается, и внутри нее возникает свободная полость, наполняющаяся кровью – каверна. Из каверны туберкулезные микобактерии с кровотоком разносятся по организму, плодя новые очаги воспаления. Первичная каверна ещё может закрыться и срастись без лечения, но если появятся новые гранулемы, а за ними новые каверны, то без медицинской помощи человек погибнет.
О вторичном туберкулезе говорят, когда переболевший человек заразился другим типом туберкулезной микобактерии и опять заболел, либо, когда ремиссия обернулась обострением. Такая ситуация больше характерна для взрослых пациентов. В легких образуются новые очаги воспаления, иногда настолько близко друг к другу, что каверны сливаются, и возникают обширные полости с экссудатом. Около 30% больных вторичным туберкулезом в тяжелой форме, несмотря на усилия медиков, погибают в течение 2-3 месяцев. И лишь у одного пациента из сотни вторичный туберкулез так же спонтанно затихает, как и возник.
Человек, страдающий вторичным туберкулезом легких, очень заразен для окружающих. При кашле с мокротой в воздух постоянно выделяются бактерии. Такого пациента госпитализируют и проводят длительное лечение комбинированными антибиотиками, которое может продолжаться до полугода. Затем ещё два года человека держат на учете у фтизиатра. И лишь потом, если рентгенологическое обследование подтвердит отсутствие новых очагов болезни, диагноз «туберкулез» окончательно снимается.

Согласно мировой эпидемиологической справке:
По количеству ежегодно уносимых жизней туберкулез на сегодняшний день уступает только СПИДу.
За 2013 год на планете Земля туберкулезом заболели 9 миллионов человек, из них полтора миллиона скончались. 550 тысяч больных – дети, из них 80 тысяч погибли.
Почти 95% случаев летального исхода туберкулеза регистрируется в отстающих и развивающихся странах Африки и Азии.
Туберкулез входит в тройку самых распространенных причин смертности женщин репродуктивного возраста (16-45 лет).
Четверть всех смертей ВИЧ-инфицированных пациентов спровоцирована туберкулезом.
По данным ВОЗ, около 480 тысяч людей, заболевших туберкулезом в 2013 году, были поражены МЛУ-ТБ – мультирезистентной формой болезни, практически не поддающейся лечению.
За период с начала девяностых годов прошлого столетия по настоящее время общемировой показатель смертности от туберкулеза снизился на 45%.
Благодаря современным методам диагностики, с 2000-го по 2013 год удалось сохранить примерно 37 миллионов жизней по всему миру.
По данным на 2013 год, из ста тысяч случаев туберкулеза в России 11,3 оканчивались летальным исходом. Это большой прогресс по сравнению с показателями 2000 года: с тех пор заболеваемость снизилась на 30%, смертность – примерно на 33%.
Последние данные на сайте Минздравсоцразвития РФ гласят, что к началу 2015 года удалось снизить печальную статистику ещё на 5,5%: теперь 10,3 из 100 000 случаев туберкулеза заканчиваются смертью пациента. Динамика в разных регионах страны неодинакова, самых больших успехов добились медики Центрального федерального округа – там смертность упала на 16,4%.
В государственном бюджете России на 2015 год заложено 4 млрд рублей на профилактику и борьбу с туберкулезом.
Туберкулез вызывают особые микобактерии, всего науке известно 74 типа таких бактерий. Термин «палочка Коха» на сегодняшний день считается устаревшим, поскольку палочек в результате мутаций стало великое множество, и все они обладают индивидуальными признаками. Живут микобактерии почти везде: в почве, в воздухе, в воде, в телах людей, животных и птиц. У человека туберкулез возникает, чаще всего, в результате заражения МБТ (Mycobacterium tuberculosis), реже - Mycobacterium bovis (коровьим видом микобактерий) и Mycobacterium africanum (африканским видом).
Палочкой туберкулезную микобактерию назвали не случайно: она тоненькая, 1-10 мкм в длину и 0,2-0,6 мкм в ширину, прямая или слегка искривленная, концы скругленные, поверхность тела может быть слегка зернистой. МБТ уникальна тем, что под воздействием различных факторов среды она может дробиться на невероятно мелкие частички, или наоборот, слепляться в причудливые гигантские спруты, а затем снова возвращаться в обычную форму и заражать людей.
Туберкулезные микобактерии долго живут вне организма-носителя. На пыльном тротуаре они остаются жизнеспособными 10 дней, между книжных страниц – 3 месяца, в воде – 5 месяцев. МБТ не любят солнечного света, но выдерживают нагревание до 80 °C Цельсия целых пять минут. В темном и сыром помещении они чувствуют себя особенно вольготно. Засушенными бактериями можно спустя полтора года заразить туберкулезом морскую свинку. А замороженными – даже спустя 30 лет!
МБТ не имеют органоидов движения – ни жгутиков, ни ресничек – поэтому остаются там, где их «высадил» носитель. Для роста и размножения им нужна температура от 29 до 42 °C Цельсия, наилучший вариант – 37-38 °C, то есть, в организме больного туберкулезом человека просто идеальные условия.

На начальной стадии туберкулез очень сложно отличить от банального ОРЗ или синдрома хронической усталости. Человек постоянно чувствует себя слабым, сонливым и разбитым. Есть не хочется, настроение подавленное, малейший стресс провоцирует бурную реакцию. По вечерам может наблюдаться легкий озноб, ночной сон неспокойный, сопровождается потливостью и кошмарами. Температура упорно держится на отметке 37,5-38 °C, появляется сухой приступообразный кашель, который особенно сильно мучает ночью и ранним утром. Первые признаки туберкулеза легких могут проявиться все вместе, а могут и по отдельности, в произвольных сочетаниях.
Рассмотрим прогрессирование симптомов более подробно:
Изменения внешности. Туберкулез придает лицу осунувшийся, бледный вид: черты заостряются, щеки проваливаются, на них горит неестественный румянец, глаза приобретают нездоровый блеск. Человек быстро теряет вес, и если на первой стадии болезни все эти признаки ещё не так очевидны, то у больных хроническим туберкулезом настолько характерный внешний вид, что диагноз не вызывает никаких сомнений.
Температура. Верный признак туберкулеза – не спадающая в течение месяца и более субфебрильная температура тела (37-38 °C), которая не объясняется никакими объективными причинами. К вечеру температура может подниматься до 38,5 °C и сопровождаться ознобом. Больной все время потеет, но с помощью этой естественной реакции организму все равно не удается снизить температуру тела до физиологической нормы, потому что инфекция снова и снова провоцирует лихорадку. Фебрильная температура (свыше 39 °C) возникает уже на поздних стадиях туберкулеза, при наличии массивных очагов воспаления в легких.
Кашель. Человек, страдающий туберкулезом легких, кашляет почти постоянно, однако в начале заболевания кашель сухой, накатывает приступами и выглядит, как нервная реакция. А затем, когда гранулемы разрастаются до каверн, и в легких скапливается экссудат, начинается обильное выделение мокроты. Кашель становится влажным, и после откашливания человек на некоторое время испытывает облегчение. Очень важно знать: если вас или кого-то из ваших близких на протяжении более чем трех недель подряд беспокоит необъяснимый кашель, не связанный с простудой, необходимо срочно обратиться к фтизиатру!
Кровохаркание. Такой опасный симптом почти наверняка говорит об инфильтративной форме туберкулеза, но диагноз необходимо дифференцировать от злокачественной опухоли легкого и острой сердечной недостаточности, поскольку для этих болезней также характерно кровохарканье. При туберкулезе кровь выделяется из дыхательных путей в небольшом количестве сразу после приступа влажного кашля с обильной мокротой. Иногда кровь льется буквально фонтаном, это говорит о разрыве каверны. Больному требуется срочная хирургическая помощь для спасения жизни.
Боль в груди. Боли под ребрами или за лопатками редко выступают первыми признаками туберкулеза. Обычно этот симптом беспокоит больных на острой и хронической стадии болезни. Если боль наблюдается в начале заболевания, то она слабо выраженная, больше похожа на дискомфорт, и проявляется ярче только при глубоком вдохе.

Симптоматика внелегочных форм туберкулеза зависит от места локализации инфекции. Хотя встречаются такие формы редко, давайте все же коротко рассмотрим их основные признаки:
Туберкулез мочеполовых органов. Общий признак туберкулеза мочеполовой системы – кровь в моче и её мутный цвет. Мочеиспускание обычно учащенное и болезненное. У женщин туберкулез может вызывать межменструальные кровотечения, деформации фаллопиевых труб и, как результат, бесплодие. Если недуг поразил репродуктивную систему, то первым признаком будут постоянные ноющие боли внизу живота и кровянистые выделения. У мужчин заболевание может локализоваться в яичках, тогда внутри мошонки развивается болезненное вздутие с экссудатом. Туберкулез мочеполовых органов диагностируют по анализу мочи и лечат теми же антибиотиками, что и туберкулез легких.
Туберкулез суставов и костей. Такая форма заболевания в современной медицинской практике встречается крайне редко, и почти всегда наблюдается у ВИЧ-позитивных пациентов. Туберкулез поражает коленные, тазобедренные суставы и позвоночник. Воспаление разрушает хрящевую ткань и межпозвоночные диски, в результате больной начинает хромать, а на спине может появиться горб. Со временем при отсутствии надлежащего лечения недуг приводит к полной неподвижности. Туберкулез костей характеризуется яркой симптоматикой и сильными болями, диагностика трудностей не вызывает.
Туберкулез ЦНС. Туберкулез мозга развивается либо у пациентов с ВИЧ-инфекцией, либо у малышей с врожденным туберкулезом. В других ситуациях трудно себе представить, чтобы болезнь довели до такой опасной и запущенной формы. Микобактерии провоцируют туберкулезный менингит, то есть, воспаление оболочки головного мозга. Реже могут возникнуть гранулемы непосредственно в мозговом веществе. Симптомы яркие: головные боли, раскоординация, шум в ушах, нарушения зрения, обмороки, судороги, реже психические расстройства и галлюцинации. Без лечения больной быстро погибает, но даже современная медикаментозная терапия не гарантирует спасения.
Милиарный туберкулез. Если микобактерии сразу же после заражения разнеслись с кровотоком по всему организму и не встретили достойного отпора от иммунной системы, может возникнуть милиарная форма туберкулеза. Она характеризуется многочисленными очагами поражения – микрогранулемами не более 2 мм в диаметре. Рентгеновский снимок такого человека выглядит, как засыпанный просом. Первые симптомы такие же, как у легочной формы туберкулеза, за исключением кашля, который может и не наблюдаться. По мере разрастания гранулем в различных органах начинаются проблемы в их работе. Воспаление может охватывать почки, печень, селезенку. Требуется длительная антибактериальная терапия.
Туберкулез органов пищеварительного тракта. Ещё одна редкая форма заболевания, характерная, в основном, для ВИЧ-инфицированных больных. Наблюдается вздутие живота, ноющие боли, запоры и поносы, кровь в каловых массах, резкая потеря веса, стойкая субфебрильная температура. В тяжелых случаях туберкулез может спровоцировать непроходимость кишечника и массивное внутреннее кровотечение. Помимо медикаментозной терапии, может потребоваться хирургическое вмешательство.
Туберкулез кожи. Диагностировать эту форму заболевания несложно: под кожей больного по всему телу появляются плотные болезненные узелки, которые прорываются при расчесывании, и из них выделяется белый творожистый инфильтрат. Лечение туберкулеза кожи производится антибиотиками по стандартной схеме.

К сожалению, заразиться туберкулезом можно, и сделать это проще, чем мы думаем. По статистике каждую секунду в мире кто-нибудь приобретает в своем организме нежеланного гостя – МБТ. Подцепить туберкулезную микобактерию можно в любом общественном месте, причем, чем чаще вы бываете в людской толчее, в общественном транспорте и в медицинских учреждениях, тем выше риск. Один больной хронической открытой формой туберкулеза за год выбрасывает в воздух около семи с половиной миллиардов бактерий и заражает примерно 15 человек. Всемирная организация здравоохранения утверждает, что треть населения нашей планеты (около 2 млрд человек) заражены туберкулезом. Тогда почему же мы до сих пор не вымерли?
Дело в том, что иммунитет здорового человека – это непроходимый барьер для миллионов микробов и бактерий, ежедневно бомбардирующих наше тело. Туберкулезной палочке тоже не дадут прижиться, и носительство, скорее всего, никогда не перейдет в болезнь. Но если организм ослаблен и уязвим, живучая микобактерия не преминет воспользоваться шансом на счастливое будущее. Простуды, стрессы, недоедание, авитаминоз и прочие благоприятные для МБТ факторы могут спровоцировать начало активной стадии туберкулеза.
Туберкулез передается четырьмя путями:
Воздушно-капельный путь. По частоте этот способ уверенно лидирует – около 98% случаев заражения туберкулезом происходит воздушно-капельным путем. За один выброс при кашле больной выделяет в окружающий воздух до трех тысяч микобактерий, причем, разлетаются они в радиусе полутора метров. Частички мокроты высыхают, но остаются заразными. Поэтому самому большому риску подвергают себя люди, подолгу находящиеся в одном помещении с больными открытой формой туберкулеза.
Контактные пути. Контактный путь подразумевает заражение от личных вещей, одежды, посуды, игрушек, полотенец и прочих предметов обихода, которыми пользуется больной. Туберкулез передается через поцелуи и половые контакты. Заразиться можно и непосредственно через кровь, если имеются раны или царапины. Известны случаи, когда хирурги и патологоанатомы приобретали болезнь у своих пациентов. Не стоит забывать и о том, что туберкулез передается людям от животных: например, заразиться можно в процессе ухода за больной кошкой или собакой.
Пищевой путь. Пищевой способ инфицирования характерен для сельской местности, где люди не сдают ветеринару на анализ молоко и мясо домашнего скота. Купить зараженные продукты можно и на рынке с рук. Если корова больна туберкулезом вымени, в молоко обязательно попадут микобактерии. О мясе больных коров и свиней и говорить нечего. Заражение пищевым путем при нынешнем уровне развития сельского хозяйства, к счастью, встречается крайне редко. Если это все же случилось, туберкулез поражает органы пищеварения.
Внутриутробный путь. Если мать больна туберкулезом легких, это вовсе не означает автоматически, что она заразит будущего малыша. Однако при обширных и хронических формах, особенно в сочетании с ВИЧ-инфекцией, риск внутриутробного заражения очень велик. Диагностировать туберкулез новорожденных помогает исследование последа – плаценты. Прогноз для таких младенцев неблагоприятный, поскольку иммунитета в организме нет, а лечения ребенок не выдержит.

Это заболевание вполне можно было назвать исчезающим в 60-80-х годах прошлого столетия. О нем надеялись забыть, как о бубонной чуме или «испанке», но в 90-х туберкулез вновь принял характер эпидемии: заболеваемость и смертность возросла в 2,5 раза и приблизилась к послевоенным показателям.
В каком-то смысле так и есть: напасть одолевает Бангладеш, Индонезию, Эфиопию, Заир, Пакистан. Но Россия в этом списке находится на 22м месте, это притом, что государств в мире больше двухсот. Получается, мы безнадежно отсталая страна.
Действительно, в подавляющем большинстве случаев туберкулез поражает легкие, но, как мы рассказали выше, этот недуг может выбрать для себя и другое место в организме. Тогда возбудитель будет выделяться во внешнюю среду не с мокротой, а с другими физиологическими жидкостями (мочой, спермой, потом, слезами, слюной и т.д.) Это стоит учитывать при контакте с людьми, имеющими подозрительные симптомы.
Такое мнение справедливо основывается на том, что раньше туберкулезом болели, в основном, заключенные, бомжи и наркоманы. Теперь в учреждениях исполнения наказаний существует строгий медицинский контроль. Зато в сфере нелегальной миграции контроля больше не стало, а проблема приобрела угрожающие масштабы. Поэтому вполне благополучный человек, ослабленный стрессами большого города, может заразиться туберкулезом в метро или любом другом общественном месте.
Чтобы вдохнуть туберкулезную палочку, совершенно необязательно стоять напротив больного, когда он кашляет. Вы можете случайно зайти в то помещение, где находился носитель, спустя несколько часов или даже дней, и подцепить заразу. Другое дело, что количество единовременно попавших в организм возбудителей играет роль. При массированной и длительной атаке иммунитет действительно может не справиться с туберкулезными бактериями.
Носителем туберкулеза является каждый третий житель планеты Земля. И только у пяти из ста носителей заболевание переходит в активную стадию. Чтобы случилось такое несчастье, требуется значительное ослабление иммунитета, например, в результате долгой простуды или хронического стресса.
Заболевание можно диагностировать с большой точностью даже на самой ранней стадии. Если носительство определяется с помощью простых тестов, то что уж говорить о болезни? Проблема лишь в том, что больные своевременно не обращаются к врачу, а вместо этого прибегают к самолечению, поставив себе диагноз «ОРЗ».
Современные антибиотики и тщательно продуманные схемы лечения позволяют твердо рассчитывать на положительный исход. Сложность представляют лишь поздно выявленные, мутировавшие и мультирезистентные формы туберкулеза. Болезнь не станет приговором, если при первых же подозрительных симптомах явиться в поликлинику и пройти простейшее обследование!
Обратная сторона заблуждения. Действительно, эффективные антибиотики с минимумом побочных эффектов в арсенале современных фтизиатров имеются, но они не гарантируют излечения мутировавших форм болезни, и терапия все равно занимает несколько месяцев.
Очень опасно НЕ прививать детей от туберкулеза и НЕ проходить ежегодную пробу Манту. Эти простые меры спасли тысячи детских жизней. Разговоры некоторых «продвинутых» родителей о том, что проблема туберкулеза преувеличена, а иммунитет ребенка не стоит лишний раз травмировать прививками, просто преступны.
Для выявления туберкулеза врачи используют следующие методики:
Массовая туберкулинодиагностика детей и подростков производится ежегодно, начиная с годовалого возраста. С помощью специального шприца или пистолета под кожу на руке или предплечье вводится 0,1 мл туберкулинового раствора, концентрация возбудителя в котором определяется, исходя из возраста и веса ребенка. Проба Манту – это не прививка от туберкулеза, а специальный тест, позволяющий судить о туберкулезном статусе пациента. Место инъекции нельзя мочить и тереть. Спустя трое суток врач или медицинская сестра оценивает результат. Для этого с помощью линейки измеряется диаметр папулы – вздутия и покраснения вокруг точки введения иглы.
Результаты пробы Манту:
5-15 мм – адекватный иммунный ответ. Свидетельствует о том, что либо ребенок подвергся контакту с возбудителем и справился с ним, либо был вакцинирован против туберкулеза, и таким способом приобрел стойкий иммунитет;
0-2 мм – отсутствие иммунного ответа. Свидетельствует о том, что либо ребенок вообще никогда не сталкивался с возбудителем, либо был привит давно, и защита от туберкулеза утрачена. Таких детей нужно ревакцинировать;
16 и более мм – неадекватный иммунный ответ. Свидетельствует о том, что либо ребенок недавно заразился туберкулезом, либо был носителем, а сейчас рискует перейти в активную форму болезни под влиянием снижения иммунитета. Таким детям требуется консультация фтизиатра.
Массовая флюорография органов дыхания – это основной метод ранней диагностики туберкулеза у взрослого населения нашей страны. Делается флюорография раз в два года и представляет собой упрощенный вариант рентгенологического исследования. Человек становится перед флуоресцентным (отсюда и название) экраном, через тело проходят слабые рентгеновские лучи, и оборудование производит фотоснимок. На нем отчетливо видны очаги туберкулезного поражения, если таковые имеются. Данные в закодированном виде заносятся в специальный журнал, а затем обрабатываются компьютером для получения фтизиатрической статистики.
Рентгенография необходима для более детального изучения очагов туберкулеза, обнаруженных на флюорографии. К этому методу диагностики прибегают и для того, чтобы развеять подозрения, если результат флюорографии сомнителен. Рентгеновские лучи вредны для человека, поэтому современные диагностические установки сконструированы так, чтобы минимизировать облучение. Не стоит отказываться от рентгена, если врач рекомендует перестраховаться – лучше быть уверенным в результатах обследования, когда дело касается такого серьезного заболевания, как туберкулез.
С 1995 года бактериологическое исследование мокроты является обязательным при обращении больного в поликлинику с жалобами на кашель. За рубежом такая диагностическая практика существует уже более сорока лет. То есть, если вы кашляете, и пришли на приём к участковому терапевту или любому другому врачу общей практики (лору, например), по закону у вас должны взять анализ мокроты и окрасить мазок по Цилю-Нильсену для выявления туберкулезных микобактерий. Учитывайте это, чтобы иметь возможность защитить свои права в случае несвоевременной диагностики туберкулеза из-за халатности медицинских работников!
Другая методика, бактериальный посев по Левштайну-Йенсену, обязательной не является, но помогает определить штамм туберкулезной микобактерии, поэтому часто применяется, несмотря на длительность. Через 1-2 месяца посев созревает, и фтизиатр может узнать наверняка, каким типом микобактерии вы заражены. От этого будет зависеть выбор антибиотиков и схема лечения.
Диагностировать туберкулез можно и по крови. Для этого производят иммуноферментный анализ, который не даёт данных о статусе заболевания (носительство, острая, хроническая форма). Он предоставляет информацию лишь о том, присутствуют ли вообще в организме возбудитель. ИФА выявляет у человека антитела к туберкулезным микобактериям. Очевидно, что такой метод диагностики актуален лишь для развитых стран с крайне низким уровнем заболеваемости. Но при всей своей примитивности ИФА может оказаться полезным для диагностики редких, внелегочных форм туберкулеза.

Лечение туберкулеза сложное и длительное, в зависимости от типа и тяжести заболевания оно продолжается до двух лет и включает в себя следующие мероприятия:
Поддерживающую медикаментозную терапию;
Хирургические вмешательства (если необходимо);
Реабилитацию в санаторно-курортных учреждениях.
В современной фтизиатрической практике применяется противотуберкулезная терапия с участием нескольких видов антибиотиков.
На данный момент актуальны три схемы лечения:
Лечение туберкулеза состоит из двух основных фаз:
Целью первой, интенсивной фазы является остановка воспалительного процесса, предотвращение дальнейшей деструкции тканей, рассасывание инфильтрата и экссудата, прекращение выведения туберкулезных микобактерий из организма в окружающую среду. То есть, врачи пытаются сделать так, чтобы человек перестал быть заразным. Это занимает, в среднем, от двух до шести месяцев.
Пролонгированное лечение туберкулеза направлено на полное заживление очагов воспаления, рубцевание поврежденных тканей и восстановление у больного крепкого иммунитета. В зависимости от характера и тяжести заболевания, терапия может продолжаться до двух лет, а в случае мультирезистентной формы туберкулеза – и до трех-четырех лет, пока рентгенологическое обследование не докажет полное затухание болезни.
Эту схему ещё называют противотуберкулезной терапией первой линии. Она была предложена в начале двадцатого века, и за долгие годы практики спасла немало жизней. Хотя сейчас уже существуют более совершенные препараты, и туберкулезная микобактерия стала более устойчивой, трёхкомпонентная схема по-прежнему актуальна, и иногда применяется.
Она состоит их следующих антибиотиков:
Парааминосалициловая кислота (ПАСК).
По мере выделения новых, мутировавших и резистентных штаммов туберкулезной микобактерии менялся и подход к лечению заболевания. На смену терапии первой линии пришла стратегия DOTS, которую приняли в 120 странах мира. Она отличается гибкостью и состоит из четырех пар антибиотиков, поэтому у врача есть возможность заменять и комбинировать препараты, добиваясь наибольшей эффективности лечения для конкретного пациента:
Стрептомицин либо канамицин;
Рифампицин либо рифабутин;
Изониазид либо фтивазид;
Пиразинамид либо этионамид.
Для лечения особо сложных, мультирезистентных форм туберкулеза к схеме DOTS добавляют один из антибиотиков второго, третьего или четвертого поколения. Чаще всего, производное фторхинолона – ципрофлоксацин. Терапия длится не менее двадцати месяцев и стоит гораздо дороже стандартной схемы лечения. Пятикомпонентная схема имеет и другой существенный недостаток – обилие побочных эффектов. Организму приходится долгие месяцы травиться сразу пятью сильнодействующими препаратами.
Но иногда даже такими жертвами не удается достичь выраженного лечебного эффекта. В крайнем случае, фторхинолоны заменяют одним из устаревших и особо токсичных антибиотиков – циклосерином, капреомицином или другим препаратом «резервного» ряда. Однако в октябре 2012 года появилась новая надежда – антибиотик бедаквилин, представленный на ежегодном съезде МСБТ. В США препарат разрешили к использованию, а Всемирная организация здравоохранения выступила с заявлением, в котором подчеркнула свою заинтересованность в получении данных о практике применения этого антибиотика для лечения туберкулеза.
Дополнительная терапия туберкулеза включает:
Иммуностимуляторы (галавит, ксимедон, глутоксим) помогают организму бороться с туберкулезной микобактерией;
Гепатопротекторы необходимы для защиты печени от разрушительного действия антибиотиков, их назначают при постоянном контроле уровня билирубина в крови;
Сорбенты (ацетилцистеин и реосорбилакт) назначают на время отмены химиотерапии в случае крайне тяжелых побочных эффектов. После небольшого периода отдыха лечения все равно приходится возобновлять;
Витамины группы B, глутаминовая кислота и АТФ нужны для предупреждения периферической нейропатии и прочих нежелательных эффектов со стороны ЦНС;
Метилурацил, алоэ вера, глюнат, ФиБС назначают во время лечения туберкулеза для ускорения процессов клеточной регенерации;
Глюкокортикоиды – крайняя мера, поскольку они обладают сильным иммуносупрессивным действием. Но иногда их все же назначают на короткий срок, чтобы заглушить слишком бурные проявления воспалительного процесса при обширном и тяжелом туберкулезе.

В запущенных случаях может потребоваться оперативное лечение туберкулеза. Вот, какие методики используются в настоящее время:
Искусственный пневмоторакс или пневмоперитонеум – сдавливание и фиксация легкого путем введения стерильного воздуха в плевральную полость. Эту методику можно назвать общим термином «коллапсотерапия». Когда легкое зафиксировано, каверны в нем постепенно срастаются, кроме того, прекращается выделение возбудителя туберкулеза, и пациент перестает заражать других людей;
Спелеотомия или каверноэктомия – резекция наиболее крупных каверн, не поддающихся консервативному лечению;
Клапанная бронхоблокация – установка миниатюрных клапанов в устья бронхов для предотвращения их слипания и нормализации дыхания больных туберкулезом;
Резекция лёгкого — удаление необратимо пораженной части лёгкого;
Лобэктомия легкого – удаление одной доли правого или левого легкого;
Билобэктомия — удаление по одной доли правого и левого лёгкого;
Пневмонэктомия, или пульмонэктомия — удаление правого или левого легкого целиком.
Автор статьи: Макарова Евгения Владимировна, врач-пульмонолог
Туберкулез легких – это заболевание, носящее инфекционную природу, характеризуется появлением в легких, специфических изменений воспалительного характера. Вызывает эту болезнь микобактерия туберкулеза, носящее также название туберкулезной палочки. Передается по воздуху, при кашле, разговоре, чихании.
Для сравнения, в воздухе соснового бора содержится всего около трехсот бактерий на 1 кубометр! Можно сказать, что атмосфера там почти стерильна, а ещё – целебна для здоровья. Спасибо за это нужно сказать фитонцидам, природным антибиотикам, источаемым соснами.
Одна из форм очагового туберкулеза – инфильтративный туберкулез, характеризуется обширной тканевой реакцией легких. В этой фазе болезни на первый план выходят симптомы в виде инфильтрации и перифокального воспаления.Причин, которые приводят к такому развитию патологического процесса, несколько. В большинстве случаев механизм.
Туберкулез костей и суставов — это заболевание опорно-двигательного аппарата, которое характеризуется прогрессирующим разрушением костей и приводит к анатомическим и функциональным нарушениям пораженных частей скелета. Заболевание имеет инфекционную природу и вызывается туберкулезными бактериями – палочками Коха, поражающими.
Туберкулез — заболевание, вызываемое палочкой Коха. Оно переносится детьми намного тяжелее чем взрослыми. В силу не сформировавшегося иммунитета, организму сложно ответить защитной функцией на инфекцию и локализовать её в одной области. Обширное поражение органов приводит к необратимым последствиям. Поэтому важно вовремя распознать болезнь и начать лечение.
О том, насколько высок риск развития заражения, можно судить исходя из характера контактов с бактерионосителем. Исходя из логических размышлений, следует, что чем меньше по времени будет занимать контакт, тем ниже риск инфицирования. Однако нельзя быть.
Туберкулез представляет собой инфекционное заболевание, которое провоцируется особыми бактериями. Они внедряются в человеческий организм и могут находиться там на протяжении всей жизни. Источником распространения туберкулезной инфекции являются люди с легочным туберкулезом в активной стадии. Для того, чтобы.